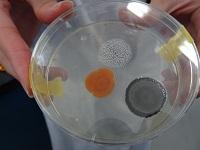

Home | 連絡先・所在地・アクセス | リンク
ブログ
1月10日 科学技術高校 授業風景
1月10日(水)、今日の科学技術高校の授業の様子を一部紹介します。
2年生理数科「理数探求」
土壌を活性化させるのにミミズは有効なのかを実験で検証。
納豆やヨーグルトを加えた土を比較。
カビを観察。
放課後、理数科3年生が、約1年半かけて行った研究の成果をまとめた資料を持参し説明してくれました。
「潮解は予測できるのか」というテーマで研究を行い、この取組のプレゼン等により大学にも合格したそうです。
「この科学技術高校で高校生活を過ごすことができたのは、私の財産です。」と語ってくれました。
「可能性の扉を開く鍵』がきっと見つかる」
☆科学技術高校☆